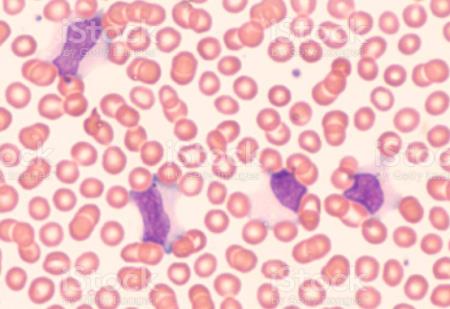
Bộ gen HIV ẩn trong các tế bào bạch cầu cung cấp mục tiêu mới để loại bỏ nhiễm trùng

Nghiên cứu tiết lộ cách vi khuẩn đường ruột thay đổi phản ứng của cơ thể đối với liệu pháp miễn dịch ung thư
Những phát hiện này có thể cung cấp thông tin cho việc thiết kế các phương pháp điều trị giúp tăng hiệu quả của liệu pháp miễn dịch ung thư ở những bệnh nhân có đáp ứng dưới mức tối ưu.